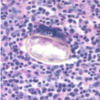

Trematodes Flashcards
(43 cards)
trematodes look like what?
flat, fleshy, leaf looking
what is another name for trematodes?
flukes
what are the most often intermediate hosts?
snails and shellfish
what is the reservoir of trematodes?
natural reservoirs
humans are what type of hosts?
how do humans become hosts?
definitive
ingestion of operculated eggs
what is a major clue to determining an infection with trematodes?
they will induce eosinophilia
what is the treatment for trematodes?
Praziquantel*
what is the major diagnostical tool to determine trematode infection?
detection of eggs in stool
what are the medically important species of trematodes?
- Fasciolopsis buski
- Fasciola hepatica
- Paragonimus westermani
- Schistosoma sp.
what is another name for Fasciolopsis buski ?
Giant intestinal fluke
how do humans acquire Fasciolopsis buski?
ingestion of water vegetation (eg.chestnuts)*
where does the giant fluke stay (what part of the intestine?)?
small intestine
what symptoms will pt present with?
abdominal pain (resembles duodenal ulcer), diarrhea
Eosinophilia *
operculated eggs in stool*
what is another name for Fasciola hepatica?
Sheep Liver Fluke
how do we acquire fasciola hepatica?
Ingestion of watercress *
the adult worm from fasciola hepatica will damage what organs?
liver, bile ducts *
when will fasciola hepatica cause hepatomegaly, eosinophilia *?
when the parasite is migrating through the liver
when will fasciola hepatica cause hepatitis, biliary obstruction?
when there is infestation of bile ducts
what will be a good diagnostic test for determining infection with fasciola hepatica?
operculated eggs in stool
what is another name for Paragonimus westermani?
Lung Fluke
how do we acquire Lung Fluke?
Eating uncooked crabmeat / crayfish (larvae) *
where will we find the adult Paragonimus westermani?
in lungs *
when the Paragonimus westermani larva migrate we will see what symptoms?
fever, eosinophilia *
what symptoms will be seen with Paragonimus westermani infection?
Cough, blood-tinged sputum *, chronic bronchitis